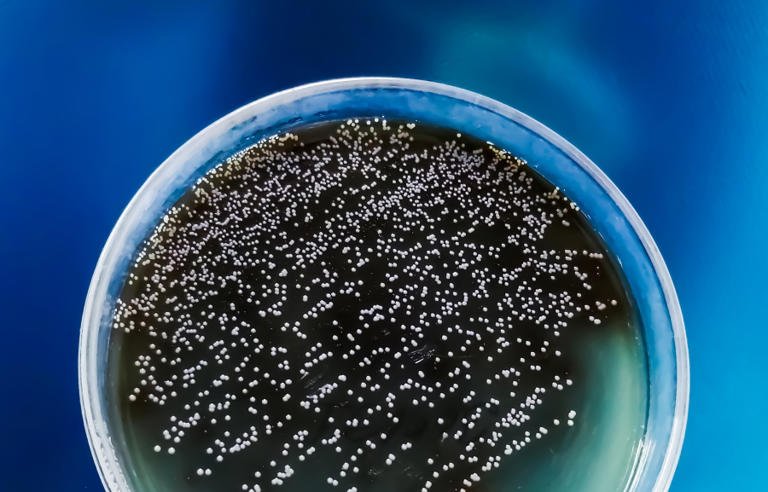

The Centers for Disease Control and Prevention has identified Candida auris as an “urgent” threat as it spreads rapidly through U.S. hospitals, tripling in just three years. The fungus is spreading “at an alarming rate,” the CDC says, but how exactly is it spreading? Click Here To Learn More




Leave a comment